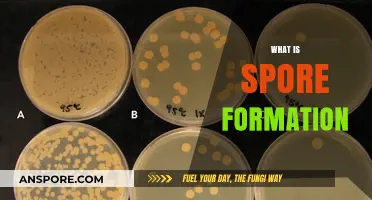
Understanding Spore Formation: A Survival Mechanism in Microorganisms

The legality of psilocybe spores, which are the reproductive units of psychedelic mushrooms, varies significantly depending on jurisdiction. In many countries, including the United States, psilocybe spores themselves are not explicitly illegal because they do not contain psilocybin or psilocin, the psychoactive compounds that are controlled substances. However, cultivating these spores into mushrooms is often prohibited, as the resulting fungi will contain these regulated compounds. Some regions, like certain states in the U.S. and countries in Europe, have begun to decriminalize or legalize psilocybin for medical or personal use, creating a complex legal landscape. It is crucial to research and understand local laws before acquiring or handling psilocybe spores to avoid potential legal consequences.
| Characteristics | Values |
|---|---|
| Legality in the U.S. | Legal in most states (47 states) for microscopy and research purposes; illegal for cultivation or consumption in all states. |
| Federal Law (U.S.) | Spores themselves are not explicitly illegal under federal law, but cultivating mushrooms from spores is illegal under the Controlled Substances Act. |
| State Exceptions (U.S.) | California, Georgia, and Idaho have specific restrictions or bans on psilocybe spores. |
| International Legality | Varies widely; legal in some countries (e.g., Netherlands, Brazil) for personal use or research, illegal in others (e.g., UK, Australia). |
| Purpose of Legality | Legal for microscopy, taxonomy, and research in many regions; illegal for recreational or cultivation purposes. |
| Enforcement | Rarely enforced for possession of spores alone, but cultivation can lead to severe penalties. |
| Decriminalization Efforts | Some U.S. cities (e.g., Denver, Oakland) have decriminalized psilocybin mushrooms, but spores remain in a legal gray area. |
| Medical Use | Spores are not directly used for medical purposes, but psilocybin (derived from mushrooms) is being researched for therapeutic use. |
| Online Sales | Legal to sell and purchase spores online in most U.S. states, often marketed as "for microscopy use only." |
| Risk of Prosecution | Low for possession of spores, but high if intent to cultivate is proven. |
Explore related products
What You'll Learn

Federal vs. State Laws
The legality of psilocybe spores in the United States is a complex interplay of federal and state regulations, creating a patchwork of rules that can confuse even the most informed individuals. At the federal level, psilocybe mushrooms are classified as a Schedule I controlled substance under the Controlled Substances Act, meaning they are deemed to have a high potential for abuse and no accepted medical use. However, the spores themselves, which do not contain the psychoactive compound psilocybin, occupy a legal gray area. Federal law does not explicitly prohibit the possession or sale of psilocybe spores, as long as they are not intended for cultivation. This loophole has allowed spore vendors to operate legally, often marketing their products for research or educational purposes.
In contrast, state laws vary widely, introducing layers of complexity for those navigating this landscape. Some states, like California and New Mexico, have followed the federal stance, neither explicitly banning nor regulating psilocybe spores. Others, such as Georgia and Idaho, have enacted stricter laws, classifying spores as illegal due to their potential use in cultivating psilocybin-containing mushrooms. For instance, in Georgia, possession of psilocybe spores can result in felony charges, regardless of intent. This state-by-state variation means that what is legal in one jurisdiction could lead to severe penalties in another, underscoring the importance of understanding local laws before acquiring or possessing spores.
For those considering purchasing psilocybe spores, it’s crucial to adopt a cautious and informed approach. First, research the specific laws in your state to avoid unintentional violations. Second, if purchasing online, verify the vendor’s reputation and ensure they comply with federal guidelines by explicitly stating their products are not for cultivation. Third, consider the ethical implications of your actions, particularly in states where the legality is ambiguous. While federal law may permit spore possession, local enforcement can still pose risks, especially in states with harsher penalties.
A comparative analysis reveals that the federal-state divide often mirrors broader debates about drug policy and individual freedoms. States like Oregon and Colorado, which have decriminalized or legalized psilocybin for medical or therapeutic use, are challenging federal norms and pushing for reform. These progressive measures highlight the growing recognition of psilocybin’s potential therapeutic benefits, such as treating depression and PTSD. However, until federal law evolves, the legal status of spores will remain fragmented, leaving individuals to navigate a system where geography determines legality.
In practical terms, anyone interested in psilocybe spores should prioritize education and compliance. For example, if you live in a state with lenient laws, such as New Mexico, you might legally purchase spores for microscopy or taxonomic study. However, if you reside in Idaho, even possessing spores could lead to criminal charges. Additionally, be mindful of dosage and intent: while spores themselves are not psychoactive, cultivating mushrooms from them would violate federal and most state laws. By staying informed and adhering to local regulations, individuals can minimize legal risks while exploring this fascinating area of mycology.
Heat's Role in Spore Staining: Enhancing Accuracy and Visualization
You may want to see also

Decriminalization Efforts in Cities
In recent years, a wave of decriminalization efforts has swept through cities across the United States, targeting psilocybe spores and other psychedelic substances. These initiatives, often driven by grassroots movements and advocacy groups, reflect a growing recognition of the therapeutic potential of psychedelics and a shift in public opinion. Cities like Denver, Oakland, and Santa Cruz have led the charge, passing ordinances that deprioritize enforcement of laws against psilocybe mushrooms and their spores. These measures do not legalize possession or distribution but redirect law enforcement resources away from prosecuting individuals for personal use, effectively decriminalizing these substances at the local level.
Analyzing these efforts reveals a strategic focus on harm reduction and public health. Advocates argue that decriminalization reduces the stigma associated with psychedelic use, encouraging individuals to seek help without fear of legal repercussions. For instance, in Denver, the first U.S. city to decriminalize psilocybe mushrooms, the ordinance specifically mentions the potential of psychedelics to treat mental health conditions like depression, anxiety, and PTSD. This approach aligns with emerging research, such as studies showing that controlled doses of psilocybin (typically 20–30 mg) can produce significant therapeutic effects when administered in a clinical setting. Cities adopting these measures often emphasize education and community support over punitive actions.
For those interested in supporting or initiating similar efforts, the process involves several key steps. First, organizing a coalition of advocates, healthcare professionals, and community leaders is essential to build momentum. Second, drafting a clear and concise ordinance that outlines the scope of decriminalization—whether it includes spores, cultivation, or possession—is critical. Third, engaging with local lawmakers through public forums, petitions, and lobbying efforts can help secure the necessary political support. Caution should be taken to address concerns about public safety and misuse, as opposition often stems from fears of unregulated access. Providing data on the low toxicity of psilocybin and its minimal potential for addiction can help alleviate these concerns.
Comparatively, the success of these city-level efforts contrasts with the slower pace of change at the state and federal levels. While cities can act swiftly due to their smaller scale and direct accountability to residents, broader legalization requires navigating complex legal and regulatory frameworks. For example, Oregon’s Measure 109, which legalized psilocybin for therapeutic use in a controlled setting, took years of advocacy and legislative work. Cities, however, have demonstrated that incremental changes at the local level can serve as a proving ground for larger reforms. By showcasing the benefits of decriminalization—such as reduced arrests and increased access to mental health treatment—these initiatives pave the way for broader acceptance.
Practically, individuals in decriminalized cities should remain informed about the specifics of local ordinances, as possession limits and cultivation guidelines can vary. For instance, while Santa Cruz’s measure allows for personal cultivation, it does not permit commercial sale. Additionally, those interested in exploring psilocybin for therapeutic purposes should prioritize safety by seeking guidance from trained professionals or participating in clinical trials. As decriminalization efforts continue to expand, staying updated on local laws and advocating for evidence-based policies will be crucial in shaping the future of psychedelic legality.
Is Milky Spore Safe for Vegetable Gardens? A Comprehensive Guide
You may want to see also

Legal Status in Other Countries
The legal status of psilocybe spores varies widely across the globe, reflecting diverse cultural, historical, and legislative contexts. In the Netherlands, for example, psilocybe spores are legal to possess and cultivate for personal use, though the mushrooms themselves are regulated. This distinction allows enthusiasts to grow their own mushrooms without fear of prosecution, provided they adhere to specific guidelines, such as not selling or distributing the harvested product. This model highlights a pragmatic approach to drug policy, prioritizing harm reduction over prohibition.
Contrastingly, countries like Australia and Sweden adopt a stricter stance, classifying psilocybe spores as illegal substances under their controlled substances acts. In Australia, possession or cultivation can result in severe penalties, including fines and imprisonment, even though the spores themselves do not contain psilocybin, the psychoactive compound. Sweden’s zero-tolerance policy extends to all forms of psychedelic substances, including spores, reflecting a broader societal emphasis on drug prevention. These examples underscore the importance of researching local laws before engaging with psilocybe spores, as ignorance of the law is rarely a valid defense.
In some jurisdictions, the legal ambiguity surrounding psilocybe spores creates opportunities for loopholes. For instance, in Brazil, while psilocybin mushrooms are illegal, spores are not explicitly regulated, allowing vendors to sell them openly for "research or educational purposes." Similarly, in Spain, private cultivation of psilocybe mushrooms is decriminalized, and spores are readily available in grow shops. These gray areas often stem from outdated legislation that fails to address modern scientific understanding or cultural shifts in attitudes toward psychedelics.
A notable trend is the growing acceptance of psilocybin for medical and therapeutic purposes, which indirectly impacts spore legality. Countries like Canada and the United States (in certain states) have begun allowing controlled access to psilocybin for research or end-of-life care, though spores remain unregulated in many cases. This evolving landscape suggests that as scientific evidence supporting psilocybin’s therapeutic potential grows, more countries may reconsider their stance on spores, potentially leading to broader decriminalization or regulation.
Practical tips for navigating these legal complexities include verifying local laws through official government sources, consulting legal experts when in doubt, and avoiding international travel with spores, as cross-border regulations are often stricter. For those in countries where spores are legal, maintaining discretion in cultivation and adhering to personal-use limits can mitigate risks. As global attitudes toward psychedelics continue to shift, staying informed about legislative changes is essential for anyone interested in this field.
Maximizing Spore Syringe Shelf Life: Storage Tips and Expiry Guide
You may want to see also
Explore related products
$31.97 $33.98

Research and Medical Exemptions
Psilocybe spores occupy a legal gray area in many regions, but research and medical exemptions are carving out pathways for their legitimate use. In the United States, for instance, while psilocybin itself is classified as a Schedule I substance, spores that do not contain the psychoactive compound are legal in most states. However, the real shift is occurring in controlled environments where scientific inquiry and therapeutic applications are prioritized. Institutions like Johns Hopkins University and Imperial College London have spearheaded studies demonstrating psilocybin’s efficacy in treating conditions such as depression, PTSD, and end-of-life anxiety. These exemptions allow researchers to cultivate mycelium and mushrooms from spores for clinical trials, provided they adhere to strict regulatory protocols.
To qualify for research exemptions, investigators must navigate a complex approval process. This typically involves submitting detailed protocols to regulatory bodies like the FDA or EMA, outlining study objectives, participant criteria, and safety measures. For example, clinical trials often exclude individuals under 18 or those with a history of psychotic disorders, as psilocybin can exacerbate underlying conditions. Dosages are meticulously calibrated, ranging from 10 to 30 mg for therapeutic sessions, administered in controlled settings with trained facilitators. Researchers must also ensure compliance with international treaties like the 1971 Convention on Psychotropic Substances, which permits scientific use under specific conditions.
Medical exemptions are emerging as a parallel track, driven by the growing body of evidence supporting psilocybin’s therapeutic potential. In countries like Canada and the Netherlands, compassionate use programs allow patients with terminal illnesses or treatment-resistant depression to access psilocybin-assisted therapy under medical supervision. These exemptions require physician endorsement and are often granted on a case-by-case basis. For instance, a patient in Canada might receive approval for a single 25 mg dose of psilocybin in a clinical setting, accompanied by preparatory and integration sessions with a psychotherapist. Such exemptions underscore the shift from prohibition to regulated access, prioritizing patient outcomes over punitive measures.
Practical considerations for those pursuing research or medical exemptions include documentation, collaboration, and ethical oversight. Researchers must maintain detailed records of spore sourcing, cultivation methods, and participant outcomes to ensure transparency and compliance. Medical professionals should collaborate with interdisciplinary teams, including psychiatrists, psychologists, and pharmacists, to design safe and effective treatment protocols. Patients seeking access through exemptions should consult with healthcare providers to understand risks, such as transient anxiety or disorientation during sessions, and benefits, like sustained improvements in mood and quality of life. As the legal landscape evolves, these exemptions serve as critical bridges between prohibition and potential legalization.
The takeaway is clear: while psilocybe spores remain illegal for recreational use in most jurisdictions, research and medical exemptions are expanding their utility in controlled, beneficial ways. These exemptions not only advance scientific understanding but also offer hope to individuals suffering from conditions resistant to conventional treatments. By adhering to rigorous standards and fostering collaboration between scientists, clinicians, and regulators, these pathways demonstrate how psychoactive substances can be integrated into mainstream medicine responsibly. As more data emerges, the line between illegality and therapeutic legitimacy will continue to blur, paving the way for broader acceptance and accessibility.
Lysol's Effectiveness: Can It Eliminate Ringworm Spores Effectively?
You may want to see also

Penalties for Possession/Distribution
The legality of psilocybe spores varies widely by jurisdiction, but penalties for possession or distribution can be severe, even in places where spores themselves are not explicitly outlawed. In the United States, for instance, federal law does not criminalize the possession of psilocybe spores because they do not contain psilocybin, the controlled substance. However, cultivating these spores into mushrooms, which do contain psilocybin, is illegal under the Controlled Substances Act. States like California, Georgia, and Idaho have gone further, explicitly banning psilocybe spores, with penalties ranging from misdemeanors to felonies depending on intent and quantity. A first-time possession charge in Georgia, for example, could result in up to one year in jail and a $1,000 fine, while distribution in California might lead to three to five years in prison.
Understanding the nuances of local laws is critical, as penalties often hinge on the perceived intent behind possession. In jurisdictions where spores are legal but cultivation is not, law enforcement may interpret the presence of growing equipment (e.g., grow kits, substrates) as evidence of intent to cultivate, escalating charges from a minor offense to a felony. For instance, in Texas, possession of spores alone might result in a Class C misdemeanor with a fine of up to $500, but if authorities suspect cultivation, the charge could jump to a felony with penalties including two to 10 years in prison and fines up to $10,000. This underscores the importance of not only knowing the law but also avoiding circumstantial evidence that could implicate cultivation.
Internationally, the landscape is equally complex. In countries like the Netherlands, psilocybe spores are legal to possess and sell, but cultivating them into mushrooms is prohibited. Penalties for cultivation can include fines of up to €41,000 and imprisonment, depending on scale. Conversely, in countries like Brazil, both spores and mushrooms exist in a legal gray area, with enforcement varying widely by region. Travelers and residents alike must research local laws meticulously, as ignorance is rarely a defense. For example, in Canada, while psilocybin remains illegal, Health Canada has granted exemptions for medical use, but possession or distribution outside these exemptions can result in penalties similar to those for other Schedule III substances, including fines and imprisonment.
Practical tips for minimizing risk include purchasing spores from reputable vendors who clearly label products as "for microscopy or taxonomic purposes only," avoiding public discussion of cultivation plans, and storing spores in a manner that does not suggest intent to grow. For those in jurisdictions where spores are illegal, even ordering them online can lead to penalties, as customs officials may intercept packages and involve law enforcement. In states like Idaho, where spore possession is a misdemeanor, fines can reach $1,000, and a conviction could impact employment or housing opportunities. Always consult a legal professional if uncertain, as the interplay between federal and state laws can create unexpected liabilities.
Ultimately, the penalties for possession or distribution of psilocybe spores reflect broader societal attitudes toward psychedelics, with enforcement often prioritizing deterrence over education. While decriminalization efforts are gaining traction in some regions (e.g., Oregon’s Measure 109 legalizing psilocybin for therapeutic use), the majority of jurisdictions maintain strict penalties. Individuals must weigh the legal risks against their intentions, whether for research, microscopy, or personal use. As laws evolve, staying informed and advocating for clearer regulations can help reduce ambiguity and mitigate the harsh consequences of unintentional violations.
Do All Bacillus Species Form Spores? Unraveling the Truth
You may want to see also
Frequently asked questions
Psilocybe spores themselves are legal in most states in the U.S., as they do not contain psilocybin, the controlled substance. However, growing mushrooms from these spores is illegal under federal law.
Yes, purchasing psilocybe spores online is legal in most U.S. states, as they are sold for microscopy or research purposes. However, laws vary by state, so check local regulations.
Yes, psilocybe spores are legal in California for microscopy and research. However, cultivating mushrooms from these spores remains illegal under state and federal law.
In the UK, psilocybe spores are legal to possess, as they do not contain psilocybin. However, cultivating mushrooms from the spores is illegal under the Misuse of Drugs Act 1971.
Psilocybe spores are legal to possess in Canada, as they do not contain psilocybin or psilocin. However, cultivating mushrooms from these spores is illegal under the Controlled Drugs and Substances Act.